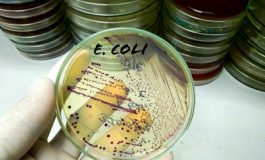
featured 2146561 265x160

Covid, presidente infermieri: "Così in 48 ore è cambiato tutto, uno scenario di guerra"
Roma, 19 feb. (Adnkronos Salute) - "Quando il tampone del primo paziente dall'ospedale San Matteo di Pavia fu mandato ad analizzare, io ero a Pavia per un master e ho seguito in diretta quello che stava accadendo. Lì abbiamo tutti realizzato che ciò di cui per i 2 mesi antece...